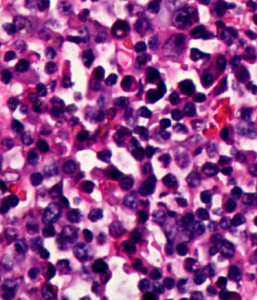
淋巴結反應性增生

概述
淋巴結是機體重要的免疫器官。各種損傷和刺激常引起淋巴結內的淋巴細胞和組織細胞反應性增生,使淋巴結腫大,稱為淋巴結反應性增生(reactivehyperplasiaoflymphnode)。其成因很多,細菌、病毒、毒物、代謝的毒性產物、變性的組織成分及異物等,都可成為抗原或致敏原刺激淋巴組織引起反應。淋巴結腫大的程度不等,有時可達10cm。鏡下,由於致病原因不同,淋巴結反應性增生的成分和分布情況不同。刺激B細胞的抗原物質主要引起淋巴濾泡增生增大,生髮中心擴大增生;刺激T細胞的抗原物質主要引起濾泡旁區淋巴細胞增生。有些抗原物質則主要引起淋巴竇內的組織細胞增生。淋巴結反應性增生為良性病變,但腫大的淋巴結無論肉眼觀或鏡下都容易與淋巴結的腫瘤混淆,但其治療和預後差別很大,應注意鑑別。病理改變
病變的淋巴結肉眼觀一般為輕度腫大,直徑多在1-2cm。組織學表現為淋巴濾泡(B細胞區)增生、副皮質區(T細胞區)增生、竇組織細胞增生三種模式以及上述三種模式的混合存在。如類風濕性關節炎(rheumatoidarthritis)病人的淋巴結以淋巴濾泡的增生為主,鏡下可見淋巴濾泡的數量增多、體積增大。在擴大的生髮中心內有較多活化的B淋巴細胞(中心細胞和中心母細胞),核分裂像多見。還可見少數胞漿豐富淺染,含有吞噬的核碎片的組織細胞散布於其中。在髓索內可見較多成熟的漿細胞。在病毒感染所致的淋巴結反應性增生(如傳染性單核細胞增多症,infectiousmononucleosis)則以副皮質區增生為主,表現為副皮質區變寬,血管增多,其中可見一些活化的、核形不規則的細胞和T免疫母細胞。竇組織細胞增生時表現為髓質淋巴竇開放,竇內充滿大量組織細胞。當腫大的淋巴結內有旺盛的反應性淋巴濾泡增生時,應注意與濾泡性淋巴瘤相區別。
類型
淋巴結反應性增生
淋巴結反應性增生非特異性反應性淋巴濾泡增生(nonspecificreactivefollicularhyperplasia)的主要特點為淋巴結腫大、淋巴濾泡增生、生髮中心明顯擴大。淋巴濾泡數量增多,不僅分布於淋巴結皮質,並可散在於皮髓質交界處和髓質內。濾泡大小形狀不一、界限明顯。生髮中心明顯擴大、增生,內有多數各種轉化的淋巴細胞,核較大,有裂或無裂,核分裂像多見,並有多數吞噬細胞,胞漿內含有吞噬的細胞碎屑。生髮中心周圍有小淋巴細胞環繞。在濾泡之間的淋巴組織內可見漿細胞、組織細胞及少數中性粒細胞和嗜酸性粒細胞浸潤。淋巴竇內的網狀細胞和內皮細胞增生。
反應性淋巴濾泡增生易與濾泡性淋巴瘤混淆,後者的淋巴結結構破壞,濾泡大小形狀相似,界限不明顯。濾泡內增生的細胞呈異型性,但類型比較一致,核分裂像較少,一般不見吞噬異物的巨噬細胞,增生的淋巴細胞為單克隆性;而反應性淋巴濾泡增生時增生的淋巴細胞為多克隆性。
巨大淋巴結增生巨大淋巴結增生(giantlymphnodehyperplasia)又稱血管濾泡性淋巴結增生(angiofollicularlymphnodehyperplasia)或Castleman淋巴結增生症或Castleman病(lymphnodehyperplasiaofCastleman;Castlemandisease)。這是一種特殊類型的淋巴結增生,不是腫瘤也不是錯構瘤。可發生於任何年齡。巨大淋巴結增生最常發生於縱隔淋巴結,也可見於肺門淋巴結及頸部、腋窩、腸系膜、闊韌帶和腹膜後淋巴結。淋巴結明顯腫大,大的直徑3~7cm,可達16cm,常呈圓形,包膜完整,界限清楚,切面呈灰白色。鏡下可分為兩種亞型1)玻璃樣——血管型(hyaline-vasculartype):最多見。巨大淋巴結增生中約90%以上屬於這種類型。患者多無症狀。淋巴結內淋巴濾泡增生,散在於淋巴結皮質和髓質內。一般淋巴濾泡和生髮中心不大。淋巴結內毛細血管增生伸入淋巴濾泡。這些毛細血管內皮細胞腫脹,血管周圍常有膠原纖維或玻璃樣物質環繞,位於淋巴濾泡中央很象胸腺的Hassall小體。多數成熟的小淋巴細胞在生髮中心周圍呈向心性排列成蔥皮樣層狀。濾泡之間的淋巴組織中也有多數血管,血管周圍有纖維組織或膠原纖維環繞,並常伴有漿細胞、免疫母細胞、嗜酸性粒細胞和組織細胞浸潤。有些病例增生的淋巴濾泡主要由小淋巴細胞組成,只有少數濾泡內有小生髮中心,稱為淋巴細胞型。這種類型最容易與濾泡性淋巴瘤混淆。2)漿細胞型(plasmacelltype):較少,約占10%。患者常伴有全身症狀,如發熱、乏力、體重減輕、貧血、紅細胞沉降率升高、血液丙種球蛋白增高和低白蛋白血症。淋巴結切除後症狀可消失。淋巴結內淋巴濾泡增生,生髮中心明顯擴大,周圍的淋巴細胞較少。生髮中心內各種細胞增生,核分裂像多見,並有許多吞噬了細胞碎屑的巨噬細胞。但中央沒有血管,也沒有玻璃樣變物質。淋巴濾泡之間有大量漿細胞,其間也可有較少數淋巴細胞、免疫細胞和組織細胞浸潤。有些病人在同一淋巴結內二種亞型的變化可同時存在。因此有些作者認為這二種亞型可能為一個過程的不同階血管免疫母細胞性淋巴結病血管免疫母細胞性淋巴結病(angioimmunoblasticlymphadenopathy)又稱免疫母細胞性淋巴結病(immunoblasticlymphadenopathy),多發生於中、老年人。主要表現為發熱,體重減輕,全身淋巴結腫大,肝、脾腫大,皮膚斑丘疹,瘙癢,並常有多克隆性高丙種球蛋白血症和溶血性貧血。免疫母細胞性淋巴結病的主要病變為全身淋巴結腫大,淋巴結直徑一般約為2~3cm,灰白色,質軟,活動,有時有壓痛。鏡下可見淋巴結的結構消失,淋巴濾泡和淋巴竇不明顯。淋巴結內有大量免疫母細胞和轉化的淋巴細胞浸潤。有時還有多數漿細胞、嗜酸性粒細胞、巨噬細胞和上皮樣細胞。毛細血管後小靜脈明顯增生呈分支狀。血管內皮細胞腫脹增生。淋巴結間質內可見無定形伊紅色蛋白樣物質沉積。除淋巴結外,肝、脾、骨髓和肺內也可見類似病變。這種疾病的原因和性質尚不清楚。有些病人在上呼吸道病毒感染後發病,有些病人發病前有用某些藥物如抗菌素的病史。過去曾認為本病是T細胞調節障礙引起的B細胞過度增生。近年來的研究發現,在很多病人是T細胞淋巴瘤。基因重組研究證實為單克隆性T細胞增生。目前認為本病可能是免疫系統功能障礙引起的克隆性淋巴細胞增生,在此基礎上出現惡性細胞株大量增生,發展成為惡性淋巴瘤。本病預後差別很大。約半數病人不經任何治療可生存2~4年,約25%用激素治療或並用其他化療藥物可緩解。有些病變為進行性,可發展為惡性淋巴瘤,預後不佳。到晚期由於免疫功能低下,多數病人死於繼發感染。
